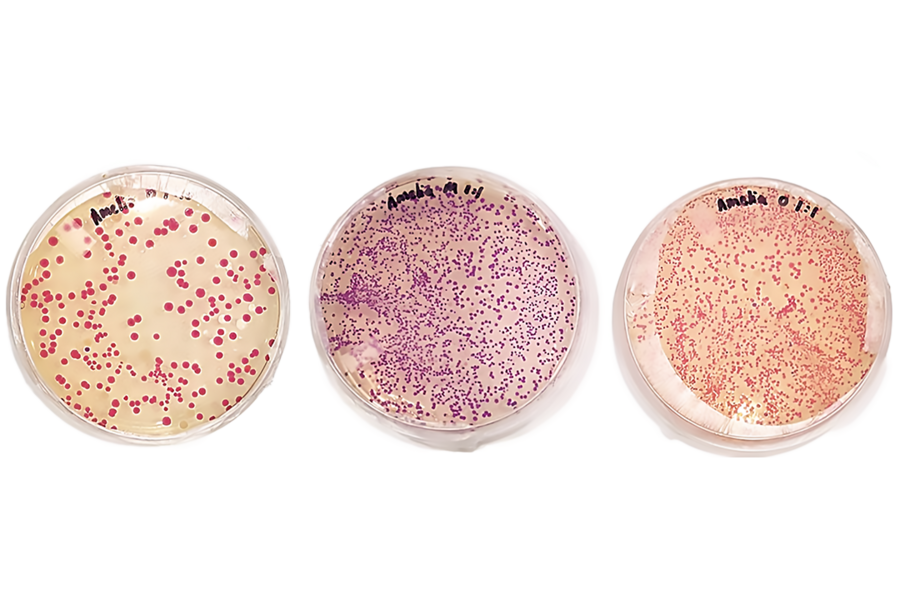

How do you keep a hands-on synthetic biology lab class going during a pandemic?
As a unique team of MIT and Harvard Medical School faculty, teaching assistants, and students describe in a new paper in Nature Biotechnology, the answer involves robots and teaching assistants working together in the lab, a new way of designing experiments, and mentoring and collaboration across multiple time zones.
David S. Kong, director of the Community Biotechnology Initiative at the MIT Media Lab, teaches MAS.S64 (How to Grow (Almost) Anything) along with Media Lab Associate Professor Joseph Jacobson and Professor George Church of Harvard Medical School. The class was inspired by MIT Professor and Center for Bits and Atoms Director Neil Gershenfeld’s popular rapid-prototyping class MAS.863 (How to Make (Almost) Anything), says Kong: “The first design of the curriculum had strong metaphorical linkages to digital fabrication, but were mapped to biology. Over the years we have evolved the course to focus on building core skillsets to enable bio-enthusiasts, regardless of their previous biology experience, to really express themselves creatively using living systems.”
Participants in the latest iteration of How to Grow (Almost) Anything, or HTGAA, developed a device that assembles viruslike protein shells for possible drug delivery, a bioreactor that produces aroma compounds for astronauts, and bioart of a world map “painted” using bacteria.
The goal has always been to share the tools and knowledge of synthetic biology with the widest possible audience, moving beyond molecular biology researchers to artists, engineers, and social justice advocates, among others.
The class, especially in its new hybrid distance-learning form discussed in the paper, has the potential to “democratize synthetic biology,” at a time when “we are the verge of converting much—or all—manufacturing, from smart materials to computing, from physics- and chemistry-based to biology-based,” says Church, who is sometimes called the “father of genomics” and a leading expert in synthetic biology and personal genomics.
“We’re living in an era where many powerful technologies are developed by and often benefit a very elite and privileged sector of society,” Kong adds. “It’s my belief that for moral reasons, and also for innovation reasons, that it’s important for diverse communities all around the world to have access to these tools and technologies and to learn how to use them safely and ethically.
Robots to the rescue
The class began in 2015 as a global education initiative, and was inspired by how Gershenfeld’s course was taught globally in a network of what is now over 2,500 community fab labs. In its first editions, HTGAA was taught to both the Fab Lab network along with the global community biology network, which Kong helps organize via the Global Community Bio Summit.
In 2019, Kong and Church first offered HTGAA to MIT and Harvard University graduate students. But in March 2020, midway through the course, the impending pandemic forced the nearly-full closure of MIT buildings and labs, the paper authors recall.
Without access to a wet lab to carry out experiments, and students unable to collaborate face-to-face, the instructors redesigned the course in 2021. Students now listened to virtual lectures from world-renowned researchers and ethics experts, but they also performed cloud-based experiment simulations. They learned how to code their final projects so that a liquid-handling robot at MIT could carry out their experiments, sometimes with the help of a teaching assistant, as they watched the process remotely.
The researchers had been expanding virtual aspects of the class before 2020, “but our commitment was accelerated by the otherwise unfortunate COVID-19 disaster,” says Church. “This empowered us to get much better at both making the mentoring as real as possible via flat screen and making robot ‘cloud labs’ easy and affordable.”
Students from six continents have since joined the MIT class, Kong says, many of them without a background in molecular biology. The class includes a “boot camp” in biology basics for those who need it, but “we really focus on skill building,” he adds. “You learn just enough theory that you can understand what you’re doing in the lab, but the key aspect is the hands-on, synthetic biology lab techniques that students acquire each week.”
Media Lab Research Assistant Eyal Perry SM ’21, lead author of the Nature Biotechnology paper, was a student in the 2020 pandemic class who returned as a teaching assistant in 2021. He said the focus on coding and simulation of experiments gave students a shared language that is unusual in lab bench biology.
“We kind of started it because of the pandemic, but I think we may have uncovered something that is fundamental for future education,” Perry says. “I think that this idea of biology through code, learning how to execute protocols and making things using robots and code, could be a new way to do things as we progress to a new era in synthetic biology.”
Global growth
The educators and students describe a future of local nodes, regional hubs and “super-core” sites that can connect students with increasing levels of technology and collaboration. In Taiwan, for instance, a HTGAA participant has already set up an active node for students, Kong says.
Kong adds that alumni have been vital in “growing the class, and as the global reach expands, we’re really building a rich and powerful innovative global learning community that goes far beyond just the course itself.”
Dominika Wawrzyniak was an HGTAA global listener in 2021 and later a global teaching assistant in 2022. Now a PhD student in biomedical engineering at New York University, she says the class is “also very rewarding for people who are already in the field itself, because you come across so many different approaches to synthetic biology that are very unique just due to the fact that people have very different backgrounds.”
Engaging designers, artists, engineers and thinkers with the practice of synthetic biology “is a better way to have a technology revolution,” Perry suggests. “We’re not trying to teach everything in this class, but really open the door, and a lot of time the door is what people are missing.”